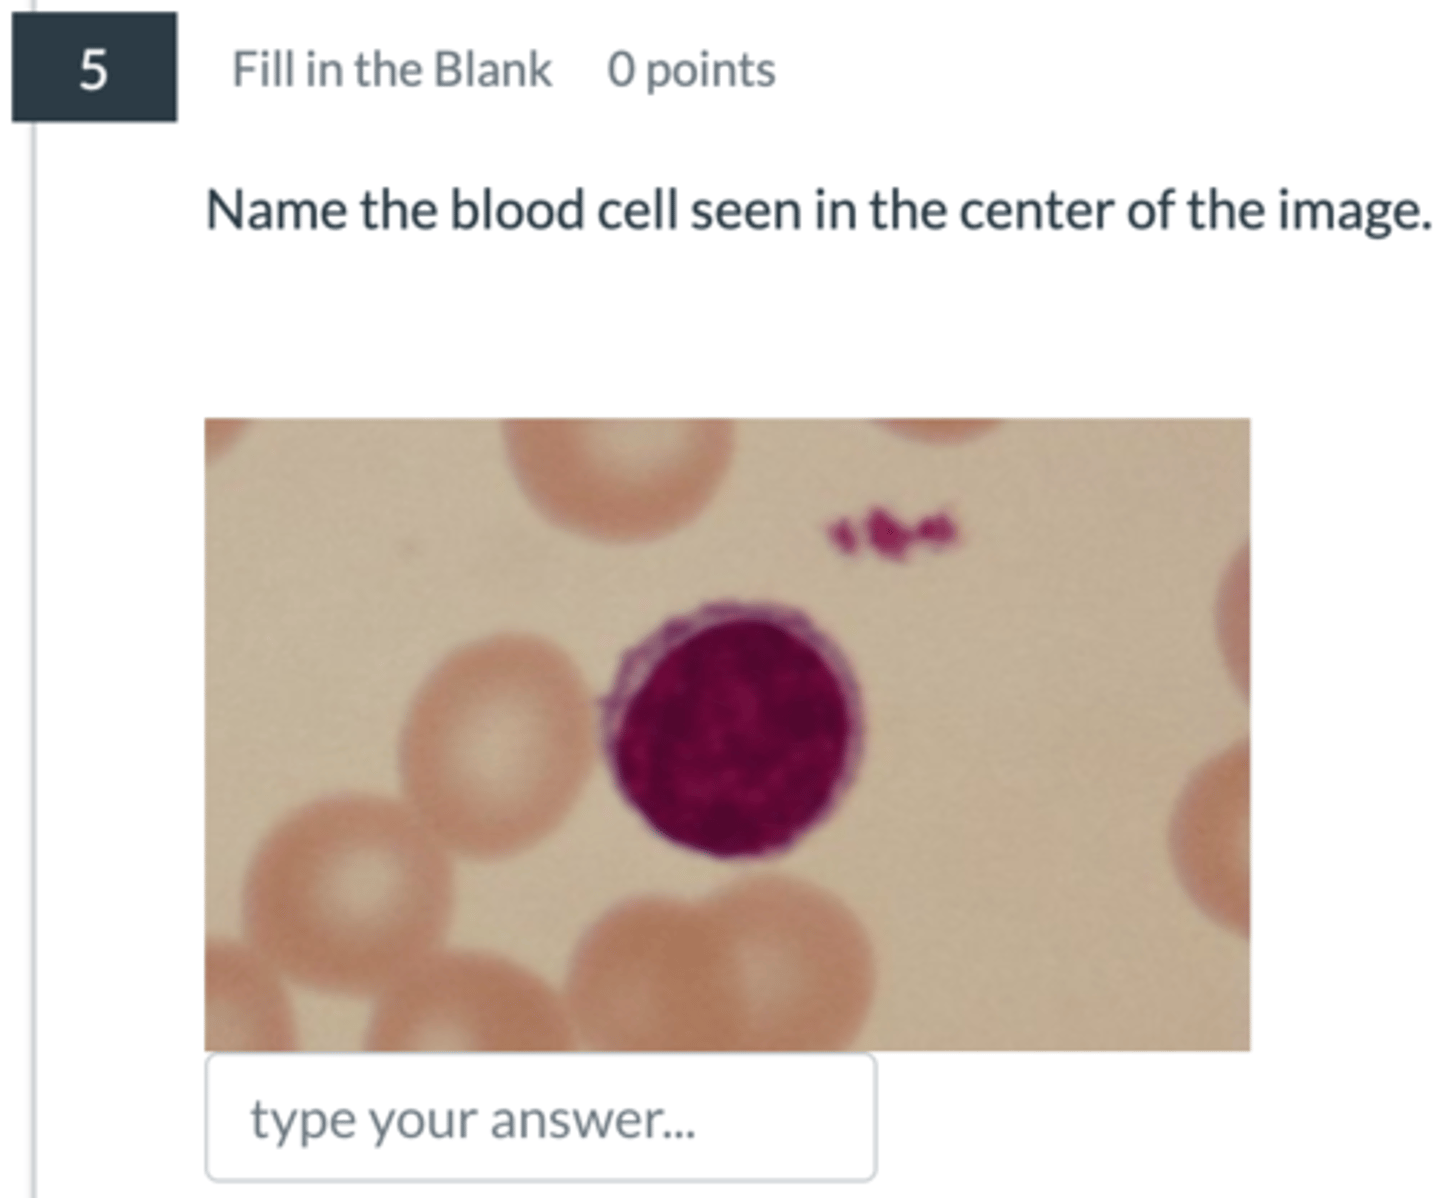
<p>5</p>

1/5
Looks like no tags are added yet.
Name | Mastery | Learn | Test | Matching | Spaced | Call with Kai |
|---|
No analytics yet
Send a link to your students to track their progress
monocyte: biggest with a fat U-shaped nucleus
1

eosinophil: many granules, pinkish cytoplasm, bilobed
2

neutrophil: odd shaped, lobed nucleus
3

basophil: very granular, blue-ish cytoplasm, hard to see nucleus
4

lymphocyte: smallest WBC, big round nucleus
5
erythrocytes: no nucleus, most common blood cell
6
